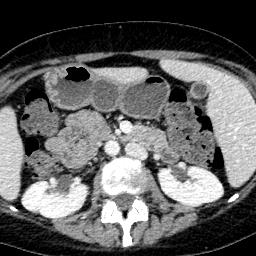
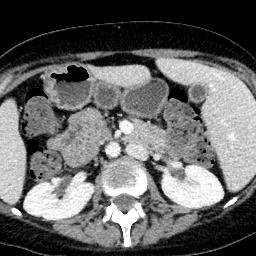
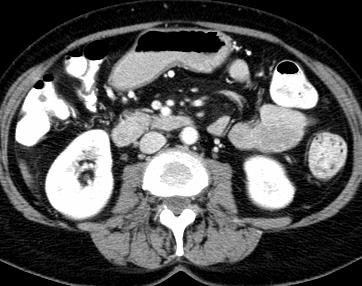
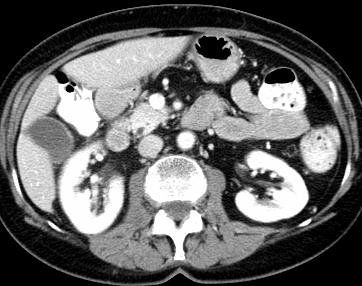

Due to the constraints of the imaging device and high cost in operation time, computer tomography (CT) scans are usually acquired with low intra-slice resolution. Improving the intra-slice resolution is beneficial to the disease diagnosis for both human experts and computer-aided systems. To this end, this paper builds a novel medical slice synthesis to increase the between-slice resolution. Considering that the ground-truth intermediate medical slices are always absent in clinical practice, we introduce the incremental cross-view mutual distillation strategy to accomplish this task in the self-supervised learning manner. Specifically, we model this problem from three different views: slice-wise interpolation from axial view and pixel-wise interpolation from coronal and sagittal views. Under this circumstance, the models learned from different views can distill valuable knowledge to guide the learning processes of each other. We can repeat this process to make the models synthesize intermediate slice data with increasing inter-slice resolution. To demonstrate the effectiveness of the proposed approach, we conduct comprehensive experiments on a large-scale CT dataset. Quantitative and qualitative comparison results show that our method outperforms state-of-the-art algorithms by clear margins.
翻译:由于成像装置的限制和操作时间成本高,计算机断层扫描通常以低切片分辨率获得。改进切片内分解法有利于人类专家和计算机辅助系统进行疾病诊断。为此,本文件制作了新的医疗切片合成法,以增加解片之间的解析。考虑到临床实践中总是没有地面真相中间医疗切片,我们采用渐进的跨视图相互蒸馏战略,以自我监督的学习方式完成这项任务。具体地说,我们用三种不同的观点来模拟这一问题:从轴视中切片间解法和从正弦和方位角度对等离子间解法。在此情况下,从不同观点中学习的模型可以提取宝贵的知识,用以指导彼此的学习过程。我们可以重复这一过程,使模型合成中间切片数据,同时增加分裂分辨率。为了证明拟议方法的有效性,我们在大规模CT数据集上进行了全面的实验。通过清晰的定量和定性的算法比较结果显示,我们的方法将超越了一种方法。